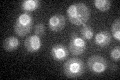
YGR202C
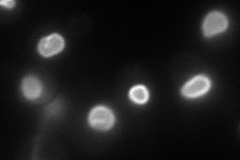
YGR202C
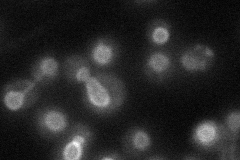
YGR202C
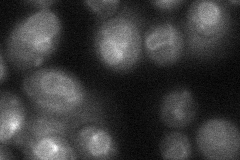
YGR202C
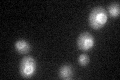
YGR202C
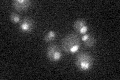
YGR202C

View description
Cholinephosphate cytidylyltransferase, also known as CTP:phosphocholine cytidylyltransferase, rate-determining enzyme of the CDP-choline pathway for phosphatidylcholine synthesis, inhibited by Sec14p, activated upon lipid-binding
Localization:
Intensity:
Fold change:
Significance:
-
C’ GFP library in SD
nuclear periphery29.04 -
N' NOP1pr-GFP in SD
nuclear periphery102.483 -
N' TEF2pr-mCherry in SD

vacuole membrane137.872 -
N' NATIVEpr-GFP in SD
nuclear periphery37.8844 -
N' TEF2pr-VC and Cyto-VN in SD
nuclear periphery34.813 -
C’ GFP library in SD+DTT
nuclear periphery20.740.71Yes -
C’ GFP library in SD+H2O2

nuclear periphery27.930.96No -
C’ GFP library in Starvation Media
nuclear periphery19.520.67Yes -
C’ GFP library on the background of Pup2-DaMP

N/A -
C’ GFP library on the background of CCT mutant

N/A0N/AYes
